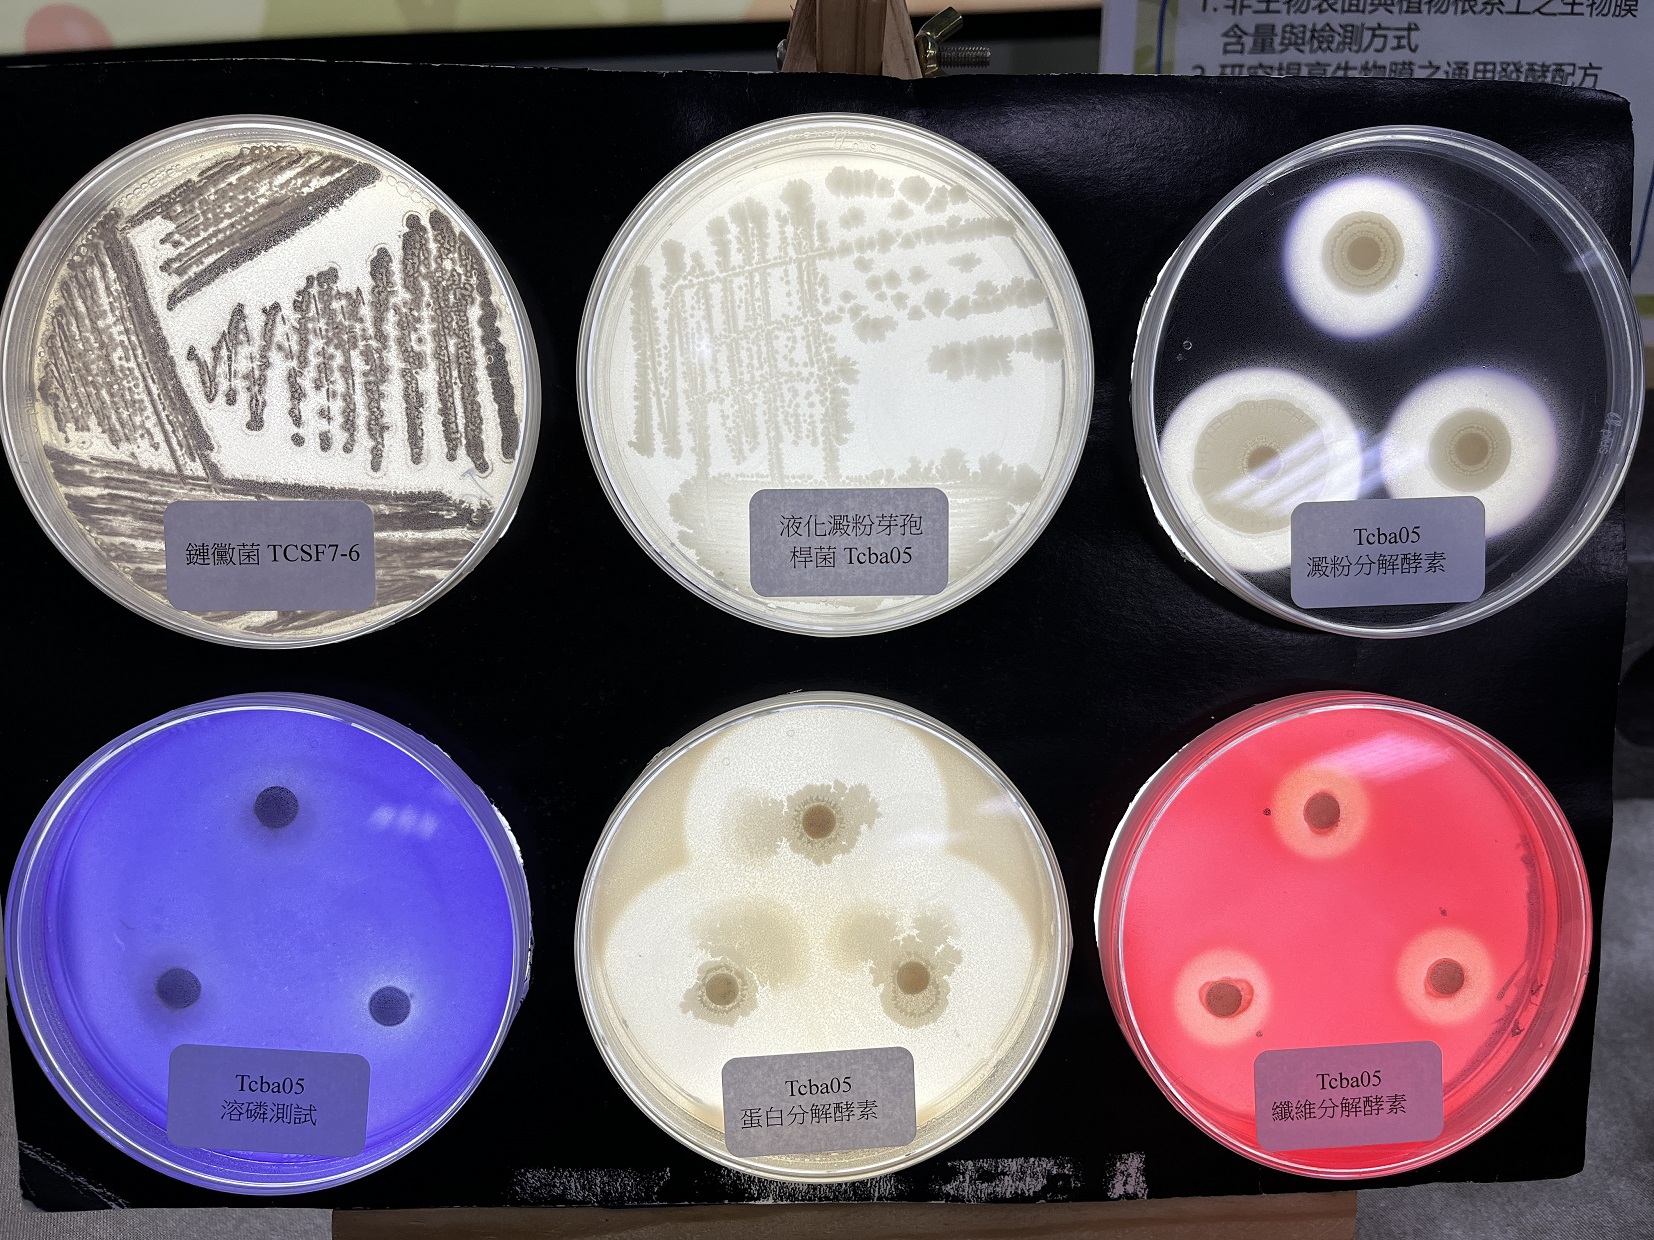

豪雨、高溫、乾旱等極端氣候對農業衝擊很大,又以蔬菜栽培首當其衝,農業部臺中區農業改良場自110年起與中興大學、農業科技研究院共同成立「耐候微生物機制篩選平臺」,跨域合作篩選出4株極具潛力的耐候微生物,可讓蔬菜在淹水逆境中存活率超過60%、乾旱逆境存活率超過55%,農場綜合應用微生物製劑,實測有助提升產量3成。
國內去年初遭遇低溫、8月後有接連3個颱風侵襲,今年也有丹娜絲、樺加沙等颱風釀災,極端氣候造成農業災損金額每年將近50億元,但透過耐候微生物製劑研發,可緩解極端氣候的非生物逆境及增加作物韌性。「耐候微生物機制篩選平臺」篩選18株耐候微生物菌株,臺中農改場再從中挑出4株具高度潛力菌株進行田間試驗,包括木黴菌TCT768、地衣芽孢桿菌TCLigB、液化澱粉芽孢桿菌Tcba05及鏈黴菌TCSF7-6。

臺中農改場今日舉辦「微生物助攻,蔬菜耐逆有新招」記者會。(攝影/游昇俯)
臺中農改場挑選4株具高度潛力菌株進行田間試驗,包括木黴菌TCT768、地衣芽孢桿菌TCLigB、液化澱粉芽孢桿菌Tcba05及鏈黴菌TCSF7-6。(攝影/游昇俯)
臺中農改場副研究員郭建志表示,田間試驗逆境條件包括讓蔬菜淹水72小時、減水20%下仍可存活及設施作物在高溫45℃以上仍可存活等。以木黴菌TCT768及鏈黴菌TCSF7-6作淹水逆境試驗,相較對照組存活率僅40%,澆灌耐候微生物「白尼龍」小白菜存活率均超過60%。

以木黴菌TCT768澆灌小白菜,淹水逆境下存活率均超過60%。(攝影/游昇俯)
以地衣芽孢桿菌TCLigB、液化澱粉芽孢桿菌Tcba05及鏈黴菌TCSF7-6做乾旱逆境試驗,相較對照組存活率僅35%,澆灌3種耐候微生物的「蜜雪兒」小白菜存活率分別為66.7%、55%及73.3%。在高溫逆境下,施用Tcba05的包心白菜的缺鈣褐化率也比對照組減少30.4%。

以鏈黴菌TCSF7-6澆灌小白菜,在乾旱逆境下存活率達73.3%(攝影/游昇俯)
彰化永靖「台盛農場」配合臺中農改場試驗,栽培小白菜、空心菜、紅莧菜等短期葉菜綜合施用耐候微生物。農場經理詹雅婷表示,耐候微生物明顯提升葉菜產量20%至30%,還能提升蔬菜養分利用效率,降低有害健康的硝酸鹽20%,增加葉菜維生素C含量15%至20%。